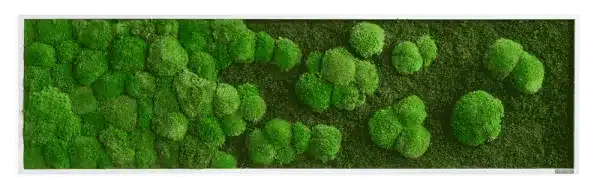

Moosbild Verlauf: Wald- und Kugelmoosbild Verlauf 140x40cm
Natürliche Ästhetik für Ihre Räume 🌿
Dieses hochwertige Moosbild vereint natürliche Materialien mit modernem Design und bringt ein Stück lebendige Ruhe in Ihr Zuhause oder Büro.
Gefertigt aus echtem, dauerhaft konserviertem Moos ist es pflegefrei, benötigt kein Licht und kein Wasser – und behält über Jahre hinweg seine Farbe und Struktur. 🌱
Jedes Stück wird in sorgfältiger Handarbeit gefertigt und ist damit ein Unikat. Die Kombination aus klarer Formensprache und natürlicher Haptik macht es zu einem stilvollen Akzent an jeder Wand. ✨
Ideal für Wohn- und Geschäftsräume, Flure, Wartebereiche oder als besonderes Geschenk.
Moosbild Verlauf: Wald- und Kugelmoosbild Verlauf 140x40cm
Das sanfte Kugelmoos verläuft stilvoll in dunkles Waldmoos auf diesem 140x40cm Moosbild, welches eine einzigartige Komposition bietet.
Ideal für die Horizontale oder waagerechte Position.
Wähle aus einer Auswahl an hochwertigen FSC-zertifizierten Rahmen in Weiß, schwarz oder Eichenoptik. Alle Rahmen sind 12 mm breit und 40 mm tief und werden in Deutschland per Hand hergestellt.
FAQs
Ja, es handelt sich um echte Pflanzen welche unter strengsten Kontrollen wachsen und dann schonend geerntet werden.
Nein, unsere Pflanzen sind
konserviert mit Glycerin,
Lebensmittel-Farbstoffen und
Salzen. Sie benötigen daher kein
Wasser und keine Pflege.
Ja, grundsätzlich schon.
Vermeiden sollte man Orte mit permanenter
Sonneneinnstrahlung. Außerdem empfehlen wir sie nicht in unmittelbarer Nähe von einem Kamin oder Ofen aufzuhängen. Alles was übermäßig Wärme entwickelt mögen unsere Pflanzbilder auf Dauer nicht. Außerdem sollten Sie nicht mit Wasser in Berührung kommen können.
Prinzipiell nicht. Bei den Dschungelbildern gibt es Pflanzenarten die nicht bekömmlich sind, aber wir wüssten nicht warum man unsere Bilder essen sollte - sie schmecken nicht, wir haben es für Sie getestet.